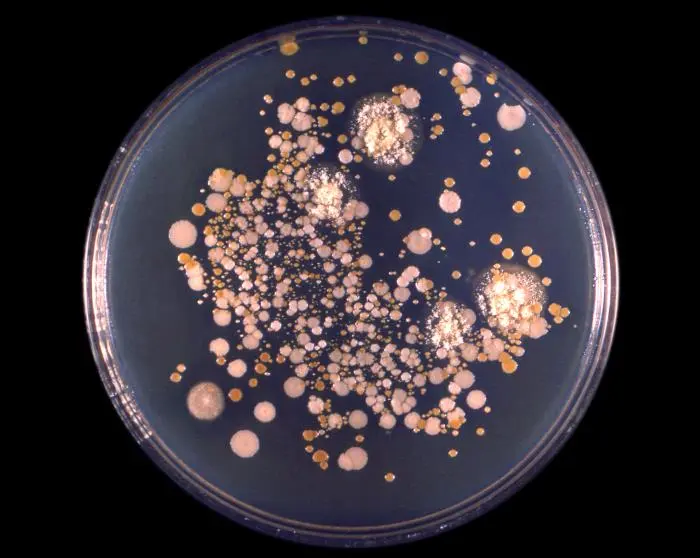

Candida Albicans

Candida albicans is an opportunistic pathogenic yeast that is a common member of the human gut flora. It can also survive outside the human body. It is detected in the gastrointestinal tract and mouth in 40–60% of healthy adults. Furthermore, it is usually a commensal organism, but it can become pathogenic in immunocompromised individuals under a variety of conditions. Candidiasis is, for example, often observed in HIV-infected patients. C. albicans is the most common fungal species isolated from biofilms either formed on (permanent) implanted medical devices or on human tissue.
A mortality rate of 40% has been reported for patients with systemic candidiasis due to C. albicans.[16] By one estimate, invasive candidiasis contracted in a hospital causes 2,800 to 11,200 deaths yearly in the US. Nevertheless, these numbers may not truly reflect the true extent of damage this organism causes, given new studies indicating that C. albicans can cross the blood–brain barrier in mice.
Mucormycosis

Mucormycosis, also known as black fungus, is a serious fungal infection usually in people who are immunocompromised. It most commonly infects the nose, sinuses, eyes and brain resulting in a runny nose, one-sided facial swelling and pain, headache, fever, blurred vision, bulging or displacement of the eye, and tissue death. Mucormycosis is usually rare, but people of any age may be affected, including premature infants.
It is spread by spores of moulds, most often through inhalation, contaminated food, or contamination of open wounds. These fungi are common in soils, decomposing organic matter (such as rotting fruit and vegetables), and animal manure. It is not transmitted between people. Risk factors include diabetes, low white blood cells, cancer, organ transplant, iron overload, kidney problems, long-term steroids or use of immunosuppressants, and to a lesser extent in HIV/AIDS.
Diagnosis is by biopsy and culture, with medical imaging to help determine the extent of disease. Treatment is generally with amphotericin B and surgical debridement. Preventive measures include wearing a face mask in dusty areas, avoiding contact with water-damaged buildings, and protecting the skin from exposure to soil such as when gardening or certain outdoor work. It tends to progress rapidly and is fatal in about half of sinus cases and almost all cases of the widespread type.
Cryptococcus Neoformans
Cryptococcus neoformans is an encapsulated yeast that can live in both plants and animals. In its yeast state, it is often found in bird excrement. Cryptococcus neoformans can cause disease in apparently immunocompetent, as well as immunocompromised, hosts. Most infections with C. neoformans occur in the lungs. However, fungal meningitis and encephalitis can occur, especially in AIDS patients. Infections with this fungus are rare in people with fully functioning immune systems. It is an intracellular pathogen that can utilize host phagocytes to spread within the body.
In humans, C. neoformans is spread by inhalation of aerosolized particles, and can spread to the central nervous system, where it can cause swelling of the brain. In the lungs, neoformans cells are phagocytosed by alveolar macrophages. However, some C. neoformans cells can survive intracellularly in macrophages. This makes this pathogen resistant to treatment.
Infection that does not affect the central nervous system can be treated with fluconazole (an antifungal) alone. For more severe infection, combination therapy can be used, however this is very expensive and remains unavailable for low and middle income countries. Mortality rate depends on the speed of diagnosis, however there are an estimated 152,000 cases of cryptococcal meningitis in HIV/AIDS patients every year with 112,000 deaths.